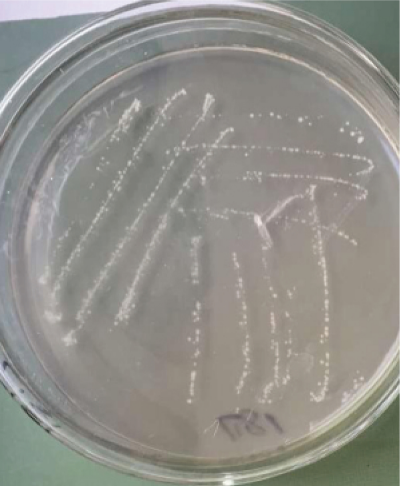
利用鱼虾原料生产富含新型生物刺激剂菌肥的关键技术 (1).jpg

废弃物资源化利用与生态循环技术
农业废弃物生物高效处理及资源化再生利用成套技术
目前有机废弃物好氧堆肥技术存在处理效率低、臭气释放严重、产品单一、效果不稳定等技术瓶颈问题。本成果技术采用自主知识产权功能微生物,实现废弃物高效生物转化与臭气达标排放,开发多元化有机肥产品,形成废弃物堆肥化新工艺和臭气减排治理的集成化技术模式。该成果从厂房规划建设,设备选型,技术攻关,产品研发、应用等方面全方位解决有机废弃物肥料化的问题。入选2019-2020年广东省农业主推技术,2019年广州市农业主推技术。
持有单位:亚洲足球体育博彩平台 农业资源与环境研究所
联系人:顾文杰
联系电话:020-85161411
电子邮箱:[email protected]
畜禽养殖废水生物-生态处理及资源化综合利用技术
针对华南地区畜禽养殖集约化程度高且粪污排放量大等现状,本技术以阻控污染物进入食物链,改善周边人居环境为目标,研发以功能生物与环保工程相结合的两相式滴滤系统为核心的系列生物-生态处理技术,主要污染物去除率达82-90%,处理后达到农田灌溉水质标准,回灌农田可以改善农产品品质,提高产量7.3%-9.6%,实现生态养殖、绿色种植、清洁环保的美丽村镇新局面。目前该技术已列入2019-2021年广东省农业主推技术和2019年广州市农业主推技术。
持有单位:亚洲足球体育博彩平台 农业资源与环境研究所
联系人:李文英
联系电话:020-85161481
电子邮箱:[email protected],[email protected]


畜禽粪污零排放资源化利用整体设计及运行技术
针对不同县(区)域、不同养殖模式提供针对性的畜禽粪污整体解决推进方案。包括养鸡场快速无臭资源化处置方案;养牛场固液分离低成本处置工艺设计;养猪场干清粪工艺改进及零排放工艺工程设计、水冲粪工艺改进及无害化-资源化利用工艺设计。在此基础上提供新建有机肥厂车间及工艺设计、现有有机肥厂工艺改造及高品质生物有机肥生产技术。2019年广东省农业主推技术。
持有单位:亚洲足球体育博彩平台 农业资源与环境研究所
联系人:逄玉万
联系电话:020-32885730
电子邮箱:[email protected]

利用鱼虾原料生产富含新型生物刺激剂菌肥的关键技术
针对鱼虾资源氨基酸酸碱法生产技术的不足与存在的关键问题,分别在原料分解转化及产生物刺激物等功能微生物的筛选复壮、原料快速发酵工艺的优化、系列产品配方的研制和规模化生产开展重点攻关,创新形成“利用鱼虾原料生产富含新型生物刺激剂菌肥的关键技术”,有效的实现对鱼虾下脚料的资源化利用,为农作物增产提供了一种来源天然、作用高效的新型肥料产品。项目已申报国家发明专利2项。
持有单位:亚洲足球体育博彩平台 农业资源与环境研究所
联系人:解开治
联系电话:020-85161411
电子邮箱:[email protected]
粪污无害化处理及资源化利用技术
将微生物菌剂接种于城市粪污,利用高温好氧堆肥技术将城市粪污进行发酵,实现城市粪污的固液合用。该技术采用特异性的微生物菌株促使堆肥迅速升温,并持续较长的高温期,以彻底杀死其中的病原菌。同时利用二次接种技术在堆肥熟化期接种抑制病原微生物生长的微生物菌剂,确保肥料的绿色、安全。该技术生产的肥料,养分及有机质含量高,可有效提升土壤肥力,改善土壤结构,优化土壤微生物群落结构,实现有机肥替代部分化肥,促进化肥减施增效。
持有单位:亚洲足球体育博彩平台 农业资源与环境研究所
联系人:顾文杰
联系电话:020-85161411
电子邮箱:[email protected]

好氧堆肥中的物理-化学强化生物除臭技术
本技术在筛选采用特定条件制备的廉价生物炭为物理材料,以脱硫企业湿式镁法脱硫渣及其它廉价镁盐为主要化学材料,辅助自研复合生物菌剂,以新改良的MAP除臭技术为主要手段,结合间歇负压曝气技术、堆体微生物群落构建技术为辅助手段,形成物理-化学-生物技术为一体的工程技术措施,达到消减堆体臭气排放量、降低外排臭气浓度、提高堆肥产品质量的目标,并已经在典型企业获得应用。2021年广东省农业主推技术。
持有单位:亚洲足球体育博彩平台 农业资源与环境研究所
联系人:逄玉万
联系电话:13826464538
电子邮箱:[email protected]

水稻秸秆半量还田半量离田技术
水稻秸秆全量还田影响下一季水稻生长,另一方面稻草饲料化、基料化、原料化等利用需求量大,而稻草收集离田效率低,导致水稻秸秆综合利用率不高、利用水平偏低。针对上述问题,团队研发了以秸秆半量收割、秸秆机械化捡拾打包离田和稻茬旋耕腐熟还田为主要内容的秸秆半量还田半量离田技术及配套措施,是一项实现水稻秸秆多途径、高价值利用,且保障耕地肥力的新型秸秆利用技术。该技术适宜广东省平原稻区。2021年广东省农业主推技术。
持有单位:亚洲足球体育博彩平台 农业资源与环境研究所
联系人:于俊红 黄巧义
联系电话:15902066799
电子邮箱:[email protected]

防病、促生功能微生物菌剂发酵工艺及产品应用
农业微生物研究团队长期致力于生防菌的研究、开发与应用。目前拥有具有拮抗番茄青枯病、番茄叶霉病、香蕉枯萎病、水稻纹枯病、小麦赤霉病、柑橘炭疽病、辣椒炭疽病、玉米炭疽病、冬瓜枯萎病、甘蔗黑腐病、棉花黄萎病、油菜菌核病的微生物菌株。经过菌株间的相互关系研究,利用多菌耦合共发酵技术,研制开发出防病、促生复合微生物菌剂。其中大部分菌种属于微生物肥料生物安全通用技术准则(NY1109~2006)中免作毒理学试验的菌种,可用于农业微生物制剂及微生物肥料登记。其主要功能为抗病、促生,同时部分菌株具有降解有机污染物的作用。
持有单位:亚洲足球体育博彩平台 农业资源与环境研究所
联系人:顾文杰
联系电话:020-85161411
电子邮箱:[email protected]


城乡废弃物昆虫转化关键技术及高值化产品研发
本技术以食腐昆虫黑水虻作为生物媒介,通过其自身的取食行为和消化作用,将城乡废弃物中的有机成分在体内进行腹化分解,用于自身的生长发育,实现有机废弃物向昆虫生物质的转化,获得黑水虻虫体和虫沙。黑水虻虫体富含丰富的蛋白质、脂肪等营养物质和甲壳素、抗菌肽等功能性物质,可进一步在饲料、医药等领域开发高值化产品,目前已开发出黑水虻鲜虫、虫体酵素产品,做为饲料应用于水产和畜禽养殖。虫沙是生产有机肥的优质原材料,目前已开发出虫沙生态有机肥。本技术在处理城乡废弃物时不会产生二次污染,资源化程度大,产物附加值高,在当前严峻的环保形势下具有较好的推广和应用价值。
持有单位:亚洲足球体育博彩平台 农业资源与环境研究所
联系人:顾文杰
联系电话:020-85161411
电子邮箱:[email protected]

磁性生物质炭制备与应用技术
本技术以废弃生物质为原料,开发出热化学处理技术制备磁性生物质炭系列材料,此类材料可应用于废水中有机污染物的吸附及类Fenton氧化降解。与传统技术比较,具有环保、高效、可磁性分离的优点,生物质废弃物的利用度达90%以上的特点。
持有单位:亚洲足球体育博彩平台 农业资源与环境研究所
联系人:涂玉婷 黄继川
联系电话:020-38469763
电子邮箱:[email protected]

基于区域土地承载力的种养一体化生态循环农业技术
针对区域内生态循环农业的情况,有机废弃物类型,聚焦产业化生产问题,开展广东省土地承载力评估,分析畜禽粪污排放量与区域土地承载力的平衡关系,研究有机废弃物循环农业、种养结合等技术模式,建立生物有机肥、复合微生物肥料、有机无机复混肥、园林绿化基质等多元化产品开发技术路线,形成以“养殖废弃物资源化利用+水肥一体化+有机肥”的生态循环农业技术模式,推动种养结合循环农业发展,提高农业资源利用效率、保护农业生态环境、促进农业绿色发展。遵循生态农业、循环经济的发展理念,本技术着重于提升区域内种植产业,引进环保产业,重点发展生态养殖业,废弃物资源化利用,构建种养加循环发展、产业内外联动互促的能源链条、产业链条、区域链条。
持有单位:亚洲足球体育博彩平台 农业资源与环境研究所
联系人:顾文杰
联系电话:020-85161411
电子邮箱:[email protected]

污染水体生态修复及再生安全农用技术
针对华南地区农业水体面积大,水旱农田复种指数高,受人为干扰严重,涉农环境问题日益严峻等现状,围绕农产品质量安全和农业生态安全的战略需求,立足于生态净化与资源利用,研发以水体微生态原位修复为核心的华南典型农业污染水体生态修复系列技术,达到再生利用水质标准。经生态净化处理后用于回灌农田和水产养殖等,通过探索新时代健康种养结合模式,为华南特色水乡低碳环保经济可持续发展提供科技支撑。
持有单位:亚洲足球体育博彩平台 农业资源与环境研究所
联系人:李文英
联系电话:020-85161481
电子邮箱:[email protected],[email protected]


食品加工业废弃物生产高浓度有机液肥技术
根据食品加工废弃物的属性和营养学特点,采用环境友好型转化工艺和独有的配制技术,生产高浓度有机液肥。经过8年的中试生产实践证明工艺成熟、生产技术可靠性强,有机液肥产品在广东周边省份得到大面积的使用。
持有单位:亚洲足球体育博彩平台 农业资源与环境研究所
联系人:彭智平 黄继川
联系电话:020-38469763
电子邮箱:[email protected]


植物源废弃物生物炭资源化利用技术
采用限氧/厌氧热解的方法,将植物源废弃物制备成生物炭和生物燃气,制得的生物炭可以直接回田改善土壤质量,也可以增值加工制备成生物炭基土壤调理剂/肥料、生物炭基育苗/花卉基质等产品,还可以通过改性等手段构建工程生物炭用于污水处理;生物质燃气可以用来加热锅炉、烘干粮食、供暖、供燃等。该处理方法工艺简单、成本低廉,有益于植物源废弃物减量化、资源化循环利用。
持有单位:亚洲足球体育博彩平台 农业资源与环境研究所
联系人:刘忠珍 魏岚
联系电话:020-38085151,85161402
电子邮箱:[email protected],[email protected]


手机版

微信


